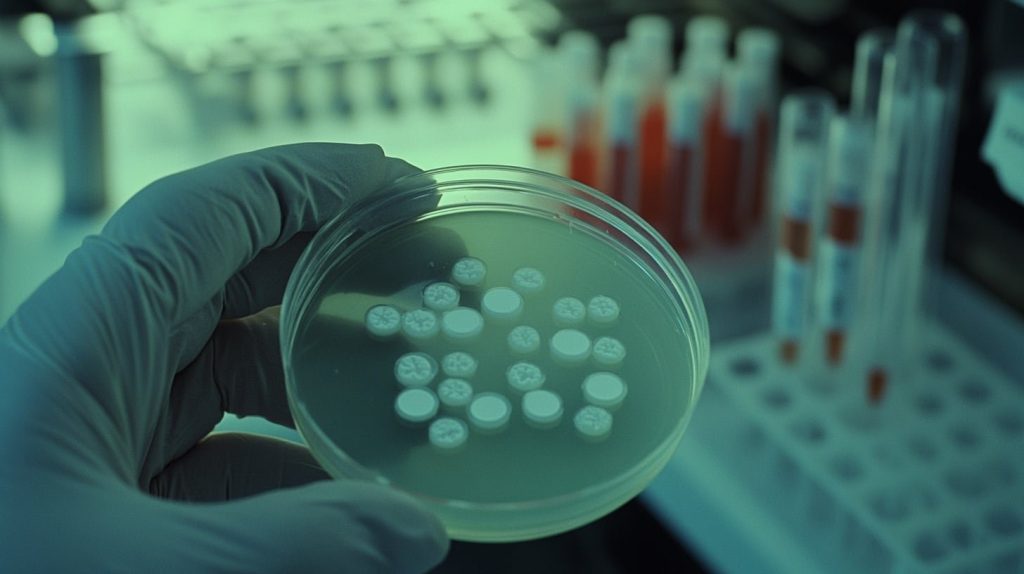

Hallan en Colombia un antepasado de la bacteria de la sífilis
Científicos descubren en la Sabana de Bogotá el genoma más antiguo de Treponema pallidum, revelando una diversidad milenaria previa a la llegada europea.
Hallan en Colombia un antepasado de la bacteria de la sífilis Leer más »